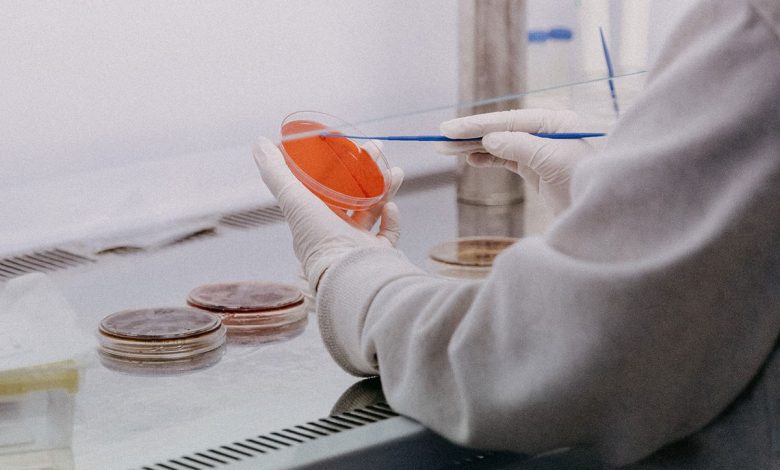

Белорусы могут сдать анализ, который определит, есть ли у них склонность к 19 заболеваниям. Об этом рассказал представитель НАН Беларуси Павел Морозик, пишет Office Life.

В генетическом паспорте будет указана предрасположенность к сахарному диабету, сердечно-сосудистым, костно-мышечным, аутоимунным и другим болезням.
«Мы можем выявлять среди белорусского населения наиболее распространенные мутации генов, определять их спектр, выявлять генетический профиль населения. А затем на основании этих данных определять повышенные риски развития тех или иных заболеваний в стране и прогнозировать их возможное развитие», – объяснил Морозик.
Анализ представляет собой соскоб со слизистой внутренней стороны щеки.
Сколько стоит генетический паспорт
Цена зависит от количества исследований. Например, оценить риск сердечно-сосудистых заболеваний можно за 323 рубля.
В результате человек узнает, есть ли у него предрасположенность к инфаркту миокарда, фибрилляции предсердий, флеботромбозу и тромбоэмболии легочной артерии.
Геном долгожителя
Белорусские генетики проводили исследования продолжительности жизни. Они собрали коллекцию ДНК 190 долгожителей. Есть также 500 образцов ДНК людей от 60 до 89 лет.
Изучив лабораторные материалы, ученые выяснили, что на продолжительность жизни влияют четыре фактора. Это генетические особенности, образ жизни, окружающая среда, социальная сфера и здравоохранение. На первые три приходится 90% влияния на долголетие человека.
Источник: Tochka.by
